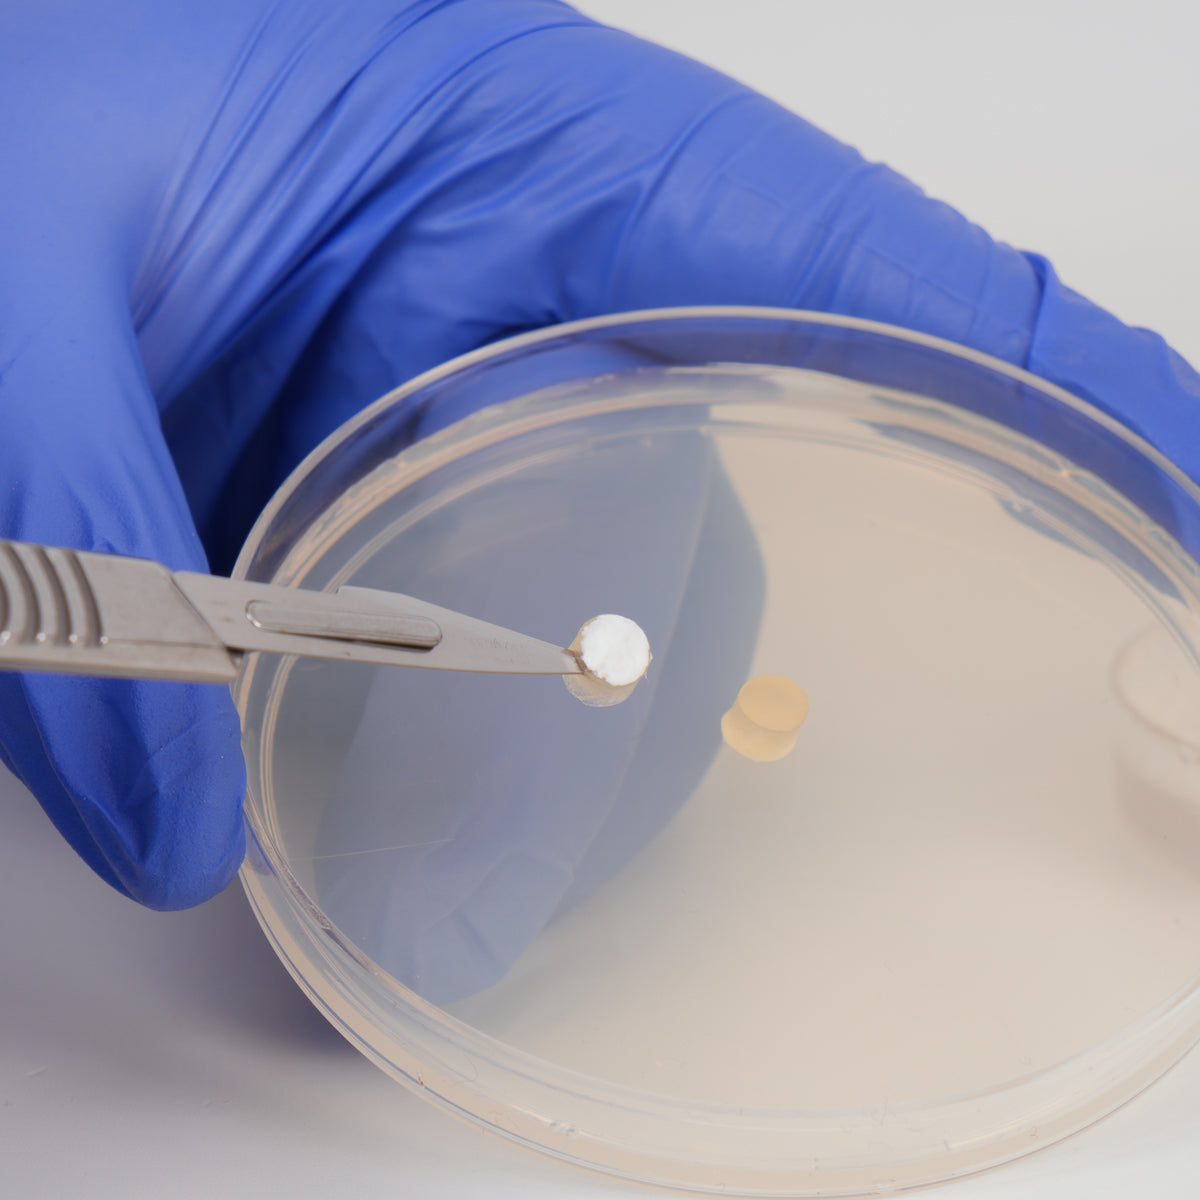

Petri Dishes, 3 Vent, Sterilized, Plastic, 90mm x 15mm (20 / 480 pack)
Lead Time
1-3 working days• Expected to ship: June 19 - June 23, 2026
Wanna make your own plates? These beautiful little circles are exactly what you need to stop your agar from just falling onto the floor and making a mess.
They arrive perfectly sterile in a clean bag. They are really high quality too, we've used cheap ones before and they are not worth bothering with.
Please note: These cannot be autoclaved, they arrive sterile ready to use. We use our used ones for spore prints after they've been washed out.
Aseptically manufactured under clean room conditions (Class 7 ISO14644) to exclude microbiological contamination. Terminally sterilised by gamma irradiation. CE marked in accordance with European Directive 98/79/EC. In vitro use only. Produced and tested in accordance with the BS611 part 2 standard, which includes stringent dimensional controls. Ideal for use in automatic plate pourers. Triple vented - aids gaseous exchange. Ideally suited for short term work.
Your payment information is processed securely. We do not store credit card details nor have access to your credit card information.